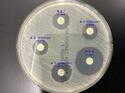

AST is key to treating infections and tackling AMR. Traditional zone of inhibition (ZOI) measurements are manual and error-prone. AI-powered tools like ZOI Pro offer fast, accurate, and affordable ZOI analysis, supporting labs, clinics, and fieldwork. Automation boosts consistency and enables smarter, scalable AST.
(White Paper)Revolutionizing Antimicrobial Susceptibility Testing: How AI and Automation Improve Zone of Inhibition Analysis
■ Introduction: Why Antimicrobial Susceptibility Testing (AST) Matters
Antimicrobial susceptibility testing (AST) plays a central role in modern infectious disease management. It allows clinicians to determine whether a specific pathogen is susceptible, intermediate, or resistant to a given antimicrobial agent, ensuring that patients receive the most appropriate therapy. In the face of growing antimicrobial resistance (AMR), AST is not only essential for individual patient outcomes but also critical for public health, antimicrobial stewardship, and surveillance.
Among the various AST techniques, the disk diffusion method (Kirby-Bauer) remains widely used due to its simplicity and cost-effectiveness. The key output of this method is the diameter of the Zone of Inhibition (ZOI)—a clear area around an antibiotic-impregnated disk that indicates bacterial growth suppression. However, traditional ZOI measurement using rulers or calipers is subject to human variability and lacks scalability, especially under high-throughput demands.
Recent advances in artificial intelligence (AI) and automation are redefining how laboratories perform ZOI analysis. These innovations bring new levels of precision, speed, and consistency to a decades-old methodology, ensuring that AST keeps pace with the demands of precision medicine and global AMR challenges.
■ Solve the Challenges of Manual Zone of Inhibition (ZOI) Measurement
Feedback from users across clinical and research environments highlights several persistent challenges with traditional, manual ZOI measurement:
(Read more.... (リンク ») )
ZOI (Zone of Inhibition) Pro - see more. (リンク »)
■ Introduction: Why Antimicrobial Susceptibility Testing (AST) Matters
Antimicrobial susceptibility testing (AST) plays a central role in modern infectious disease management. It allows clinicians to determine whether a specific pathogen is susceptible, intermediate, or resistant to a given antimicrobial agent, ensuring that patients receive the most appropriate therapy. In the face of growing antimicrobial resistance (AMR), AST is not only essential for individual patient outcomes but also critical for public health, antimicrobial stewardship, and surveillance.
Among the various AST techniques, the disk diffusion method (Kirby-Bauer) remains widely used due to its simplicity and cost-effectiveness. The key output of this method is the diameter of the Zone of Inhibition (ZOI)—a clear area around an antibiotic-impregnated disk that indicates bacterial growth suppression. However, traditional ZOI measurement using rulers or calipers is subject to human variability and lacks scalability, especially under high-throughput demands.
Recent advances in artificial intelligence (AI) and automation are redefining how laboratories perform ZOI analysis. These innovations bring new levels of precision, speed, and consistency to a decades-old methodology, ensuring that AST keeps pace with the demands of precision medicine and global AMR challenges.
■ Solve the Challenges of Manual Zone of Inhibition (ZOI) Measurement
Feedback from users across clinical and research environments highlights several persistent challenges with traditional, manual ZOI measurement:
(Read more.... (リンク ») )
ZOI (Zone of Inhibition) Pro - see more. (リンク »)
このプレスリリースの付帯情報
本プレスリリースは発表元企業よりご投稿いただいた情報を掲載しております。
お問い合わせにつきましては発表元企業までお願いいたします。
お問い合わせにつきましては発表元企業までお願いいたします。
ZOI (Zone of Inhibition) Pro
ZOI (Zone of Inhibition) Pro 